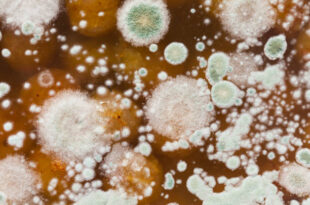

उम्र बढ़ने के साथ हड्डियों में थोड़ी बहुत अकड़न या थकान होना सामान्य माना जाता है, लेकिन अगर 30 साल की उम्र के बाद बार-बार या लगातार हड्डियों में दर्द हो रहा है, तो इसे नजरअंदाज करना खतरनाक हो सकता है।डॉ. कहते हैं, “आजकल युवाओं में भी कमजोर हड्डियां, विटामिन की कमी और ऑटोइम्यून बीमारियां देखी जा रही हैं। ऐसे …
Read More »Business Sandesh
टाइप 2 डायबिटीज महिलाओं में दिल की बीमारी का खतरा कैसे बढ़ाती है? एक्सपर्ट से जानें पूरी जानकारी
डायबिटीज केवल ब्लड शुगर की बीमारी नहीं है, यह पूरे शरीर को प्रभावित कर सकती है, खासकर दिल को। एक्सपर्ट्स मानते हैं कि टाइप 2 डायबिटीज से पीड़ित महिलाओं में हार्ट डिजीज का खतरा पुरुषों की तुलना में दोगुना तक हो सकता है। डॉ. बताती हैं, “डायबिटीज महिलाओं के दिल की धमनियों पर धीरे-धीरे असर डालती है, जिससे हाई ब्लड …
Read More »घरों में किन जगहों पर पनपता है फंगस? पहचानें फंगल इन्फेक्शन और बचाव के तरीके
बारिश का मौसम हो या नमी से भरा कमरा—इन स्थितियों में फंगस (Fungus) सबसे तेजी से पनपता है। कई बार हम इसे दीवारों या कपड़ों की बदरंग सतह समझकर नजरअंदाज कर देते हैं, लेकिन यही फंगस हमारे स्वास्थ्य के लिए खतरनाक बीमारियों की वजह बन सकता है। एम्स (AIIMS) के माइक्रोबायोलॉजिस्ट डॉ. नीरज सिंह बताते हैं, “घर के नम कोनों …
Read More »क्या बच्चों में भी थायराइड हो सकता है? जानिए कारण, लक्षण और बचाव के उपाय
थायराइड को आमतौर पर वयस्कों की बीमारी माना जाता है, लेकिन क्या आप जानते हैं कि बच्चों में भी थायराइड हो सकता है? यह स्थिति उनकी शारीरिक और मानसिक विकास को प्रभावित कर सकती है।डॉ. के अनुसार, “थायरॉयड हार्मोन बच्चों के मस्तिष्क विकास, ऊंचाई और मेटाबॉलिज्म में अहम भूमिका निभाता है। इसकी कमी या अधिकता बच्चों की सेहत को लंबे …
Read More »दिमाग का मूड बिगाड़ सकती है पेट की गड़बड़ी – जानिए मेडिकल वजह
क्या आपने कभी सुना है कि “पेट में घबराहट हो रही है” या “कुछ गड़बड़ लग रही है पेट में”? ये सिर्फ कहावतें नहीं, बल्कि विज्ञान से जुड़ी हकीकत है। हमारे पेट यानी गट (Gut) को अब मेडिकल साइंस में ‘सेकेंड ब्रेन’ कहा जाने लगा है। गैस्ट्रोएंटरोलॉजी और न्यूरोलॉजी विशेषज्ञ बताते हैं कि कैसे पेट और दिमाग के बीच गहरा …
Read More »जानिए शरीर में मैग्नीशियम की कमी क्यों होती है और इससे क्या असर पड़ता है?
मैग्नीशियम एक ऐसा खनिज तत्व है जो शरीर की सैकड़ों जैविक क्रियाओं में भाग लेता है — मांसपेशियों के संकुचन से लेकर नर्व सिग्नल, ब्लड शुगर कंट्रोल और हड्डियों की मजबूती तक। लेकिन आजकल की तनावभरी, प्रोसेस्ड फूड पर आधारित जीवनशैली के चलते लोगों में मैग्नीशियम की कमी (Magnesium Deficiency) तेजी से देखने को मिल रही है। डॉ. बताते हैं, …
Read More »बारिश के मौसम में कौन-से आटे की रोटी खानी चाहिए? जानिए डाइटिशियन की सलाह
बारिश का मौसम अपने साथ उमस, नमी और बीमारियों का खतरा लेकर आता है। इस मौसम में शरीर की पाचन शक्ति थोड़ी कमजोर हो जाती है, इसलिए खानपान पर खास ध्यान देने की जरूरत होती है। खासकर रोटियों में इस्तेमाल होने वाले आटे का चुनाव बहुत अहम हो जाता है, क्योंकि वही शरीर को जरूरी फाइबर, ऊर्जा और पोषण देता …
Read More »हर कुछ दिनों में बार-बार बुखार आना किन बीमारियों का संकेत है? एक्सपर्ट से जानें सही जानकारी
बुखार आमतौर पर संक्रमण का संकेत होता है और एक-दो दिन में ठीक हो जाता है। लेकिन अगर हर कुछ दिनों में बुखार बार-बार आता है, तो यह सिर्फ मौसमी वायरल नहीं, बल्कि किसी अंदरूनी या क्रॉनिक बीमारी का लक्षण हो सकता है। डॉक्टरों के अनुसार, इस तरह के “रिलैप्सिंग फीवर” को हल्के में लेना खतरनाक हो सकता है। मेडिसिन …
Read More »पेट की कौन-सी बीमारी बढ़ाती है वजन? जानिए कारण और बचाव के तरीके
वजन बढ़ना अक्सर गलत खानपान और जीवनशैली से जोड़ा जाता है, लेकिन क्या आप जानते हैं कि कुछ पेट से जुड़ी बीमारियां भी वजन बढ़ाने का कारण बन सकती हैं? विशेषज्ञों के अनुसार, कई बार शरीर में अंदरूनी गड़बड़ियां मेटाबॉलिज्म को प्रभावित करती हैं, जिससे वजन अनचाहे रूप से बढ़ने लगता है। डॉ. बताते हैं, “लोग समझते हैं कि पेट …
Read More »घटाएं वजन बिना मेहनत, बस पिएं अनार छिलके की चाय
जब भी आप अनार खाते हैं, तो उसके लाल रसीले दानों का स्वाद तो लेते हैं लेकिन उसके छिलकों को बेकार समझकर फेंक देते हैं। जबकि आयुर्वेद और आधुनिक विज्ञान दोनों यह मानते हैं कि अनार के छिलकों में कई औषधीय गुण होते हैं, जो खासकर वजन घटाने, पाचन सुधारने और इम्यूनिटी बढ़ाने में सहायक हैं। इन छिलकों से तैयार …
Read More » Business Sandesh Indian Newspaper | Articles | Opinion Pieces | Research Studies | Findings & News | Sandesh News
Business Sandesh Indian Newspaper | Articles | Opinion Pieces | Research Studies | Findings & News | Sandesh News